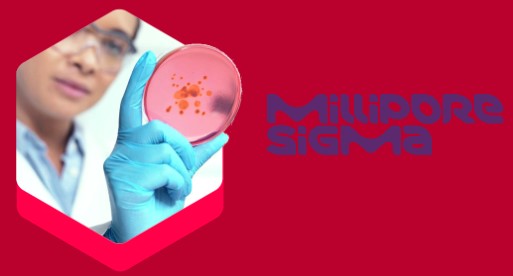

DISTRIBUCIONES OFICIALES

DISTRIBUCIONES OFICIALES

Es una empresa global de ciencia y tecnología líder en sectores de salud, ciencias de la vida y electrónica. Su innovación y desarrollo están enfocados en mejorar la calidad de vida a través de soluciones avanzadas en medicamentos, biotecnología, investigación científica y materiales de alta tecnología.
Nuestras líneas exclusivas:

Su portfolio ofrece una amplia cartera de materiales para laboratorio y producción con soporte técnico y científico, que demuestra nuestra búsqueda compartida de progreso científico. CRISPR/Cas Tecnología para la edición de genoma. Medios de cultivo celular. Síntesis orgánica y productos químicos. Tinción microscópica, tintes y anticuerpos de diagnóstico.
Ofrece un porfolio de materiales líderes para la preparación, separación, filtración y pruebas de ensayo de productos y tecnologías arraigadas en calidad, fiabilidad, procesos comprobados y experiencia normativa. Cultivo celular, cromatografía y preparación de muestras de proteínas. Detección y cuantificación de proteínas. Medios y componentes de la microbiología. Filtración estéril a gran escala.

Los sistemas Milli-Q® combinan tecnologías avanzadas para el control y purificación del agua. La selección del sistema adecuado depende de factores como la disponibilidad de agua, el volumen requerido, los niveles de certificación y otros requisitos específicos. Nuestros especialistas en purificación de agua están disponibles para asesorarte y diseñar el sistema de agua ultra pura más adecuado para tus necesidades.

El portfolio de productos analíticos Supelco está diseñado y creado por químicos analíticos para
brindar fiabilidad. Esto incluye: Solventes para el análisis instrumental Columnas de cromatografía (HPLC, GC), Reactivos Karl Fischer, Material de referencia, Portfolio de análisis de agua y alimentos (tiras
reactivas, kits e instrumentos).



RESEARCH
Insumos y soluciones para investigación, desarrollo y control en entornos de laboratorio.
BIOMONITORING
Control microbiológico preciso para asegurar calidad y confiabilidad en procesos productivos.
LAB WATER
Sistemas de purificación de agua para garantizar resultados consistentes y libres de interferencias.

DISTRIBUCIONES OFICIALES

Somos socios estratégicos y distribuidores oficiales de marcas reconocidas a nivel internacional abasteciendo insumos y equipamiento a industrias, organismos públicos y sectores clave en toda la región.








